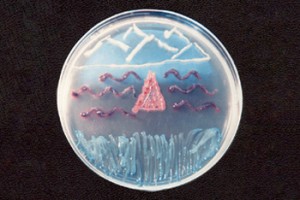
Mug-Plus

|
MICROKIT® MUGPLUS: Agar cromogénico para E. coli (colonias azules -olas-) y demás coliformes (colonias rosas -surf-). Campylobacter y Shigella crecen con colonias verdes (hierba) y otros Gram negativos con colonias crema (Pseudomonas -montañas-). |
https://www.microkit.es/fichas/MUGPLUS-COLIFORM-E-COLI-AGAR-CCA.pdf
Prepárese para más de una sorpresa informativa cuando vea nuestro video sobre los medios Cromogénicos: https://www.youtube.com/watch?v=-JVPVWxY8ZE&t=271s

hola mi consulta es como se informa E. coli si es presencia o ausencia y los coliformes totales si es recuento de UFC/ ml o g ? me podrian de ejemplos de modelos de informe de laboratorio le agradeceria mucho asi les puedo empezar a comprar el medio de cultivo
Buenos días
Respondemos a su consulta desde nuestro correo general.
Muchas gracias por visitar nuestro blog y contactar con nosotros. Un cordial saludo